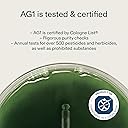
Thumbnail 5

We remain fully operational. Our teams are working around the clock to ensure your deliveries continue safely.
Customer Services
Copyright © 2025 Desertcart Holdings Limited

🌿 Elevate your daily ritual with AG1 — the nutrient boost your busy life deserves!
AG1 Greens Powder Supplement is a research-backed, all-in-one daily health formula featuring 70+ vitamins, minerals, gut-friendly bacteria, and botanicals. Designed for adults 18+, it supports digestion, energy, and immune health while fitting seamlessly into vegan, keto, paleo, and gluten-free diets. With no artificial additives and rigorous third-party testing, AG1 delivers clean, potent nutrition in a delicious pineapple-vanilla powder.





| Units | 360.0 gram |
| Brand | AG1 |
| Format | Powder |
A**H
Everyone needs AG1!
I’ve been taking AG1 for a few months now and I cannot describe to you how amazing I feel throughout the day. On top of that, I sleep better and I haven’t got sick since I’ve been taking it. It’s now a great part of my morning routine since I don’t eat breakfast, it’s an easy and quick delicious and healthy thing to do consume first thing in the morning. As a nice bonus, it’s a lovely unboxing experience and the packaging feels high quality and durable. Everyone should be drinking this!
M**1
Pretty good....
After one moth it looks and feel pretty good but I'm not 100% is the best on the market I have to tested for a bit longer.
R**S
Awesome
It’s a great product. Quick delivery too.
C**F
Jury is out just yet
This is the 2nd purchase for my husband. He thinks it’s making a difference hence splashing out for another months supply as that’s how long they suggest it takesVery expensive and I didn’t need the scoops or the bottle as we had them from the first order. Had a look on eBay and there are quite a few bottles on there which suggests that I’m not the only one who would just buy the powder
T**S
Healthy body and mind
Bought it for my mate who's a health fanatic, he loves it said after zfew days of starting it he could feel the difference, more relaxed and calm
A**4
Don’t work, not worth the price.
Expensive, and don’t feel good after using it.Smell is off putting, taste is just off. Mixed well. Didn’t notice a change after use.
F**Y
Greeeat
Great product, makes me feel so energetic and help with my exercise routine. Love it.
A**N
AG1
Absolutely rotten taste, it made me feel nauseous and want to throw up. I reduced the strength but it was puke.,.I tried to take it but didn’t finish the pack, couldn’t face it but it is good. I just couldn’t tolerate it.
Trustpilot
4 days ago
2 weeks ago